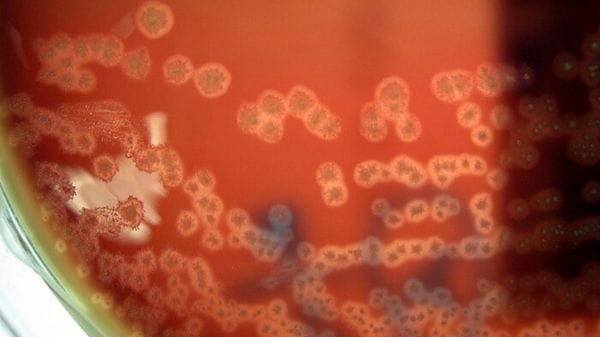
I primi batteri programmati per divorare i tumori dall'interno

Problema al cargo russo con i rifornimenti per la Stazione Spaziale
Problema al cargo russo Progress in viaggio verso la Stazione Spaziale Internazionale: poco dopo il lancio, avvenuto 12:59 italiane del 22 marzo dal cosmodromo di Baikonur in Kazakistan, una delle antenne necessarie per l' attracco automatico non si è aperta …